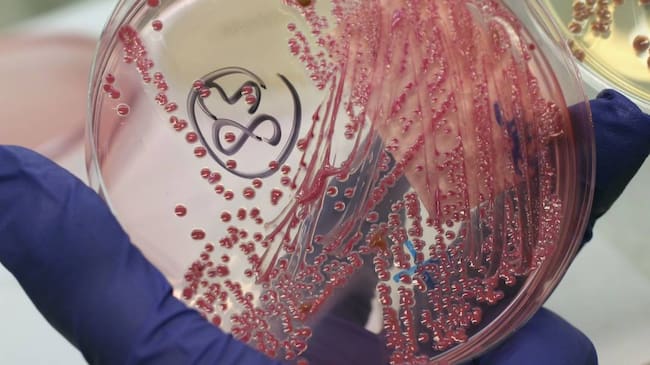
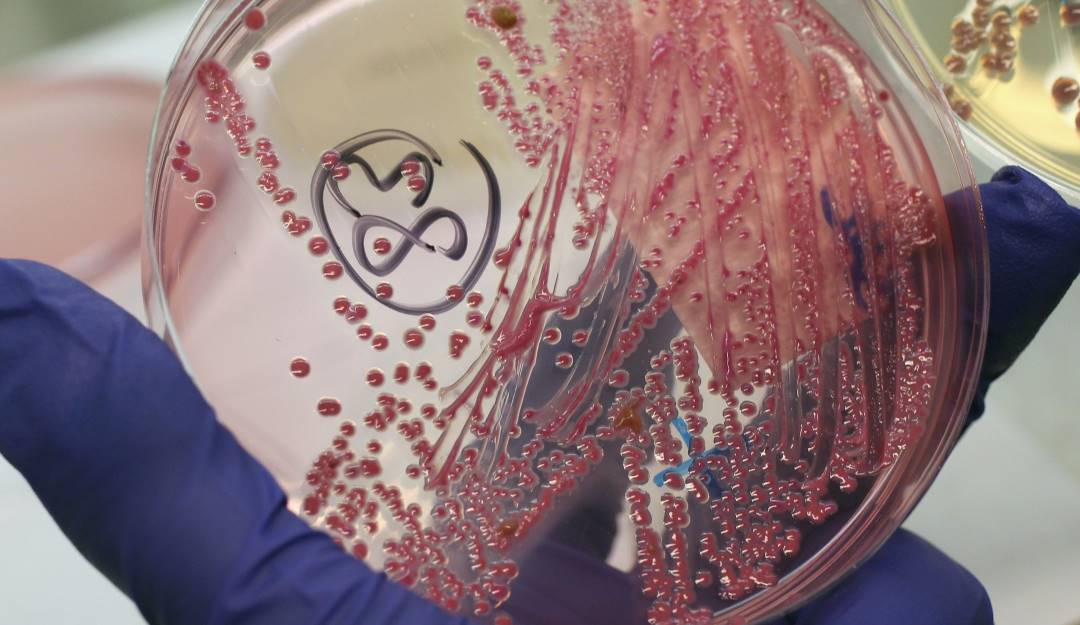
Estudio y análisis de muestras de bacterias.            Foto: Getty

Detectan bacteria que causa enfermedad potencialmente mortal en EE.UU.
La bacteria Burkholderia pseudomallei causa la enfermedad melioidosis que es endémica en Tailandia y el norte de Australia.
Estudio y análisis de muestras de bacterias. Foto: Getty
El Centro para el Control y la Prevención de Enfermedades de Estados Unidos (CDC) publicó una alerta tras la detección de la bacteria Burkholderia Pseudomallei en muestras de agua y de tierra en la costa del golfo de Mississippi.
La emisión de la alerta ocurre no solo por ser la primera vez que se detecta la bacteria en suelo estadounidense, sino que también es la causante de la enfermedad melioidosis, que también es conocida como enfermedad de Whitmore y es endémica de Tailandia y el norte de Australia.
Según datos de la Librería Nacional de Medicina de Estados Unidos, esta enfermedad causa la muerte del 10% al 50% de quienes la padecen.
Pese a ser una enfermedad potencialmente mortal, las personas que entran en contacto con la bacteria no desarrollan la enfermedad a no ser que tengan condiciones que pueden agravar su estado como enfermedades pulmonares, renales, inmunosupresoras, diabetes o consumo excesivo de alcohol.
Eddy Mosquera
Periodista Internacional de Caracol Radio desde 2018. Cubre temas internacionales, tecnológicos y relacionados...




